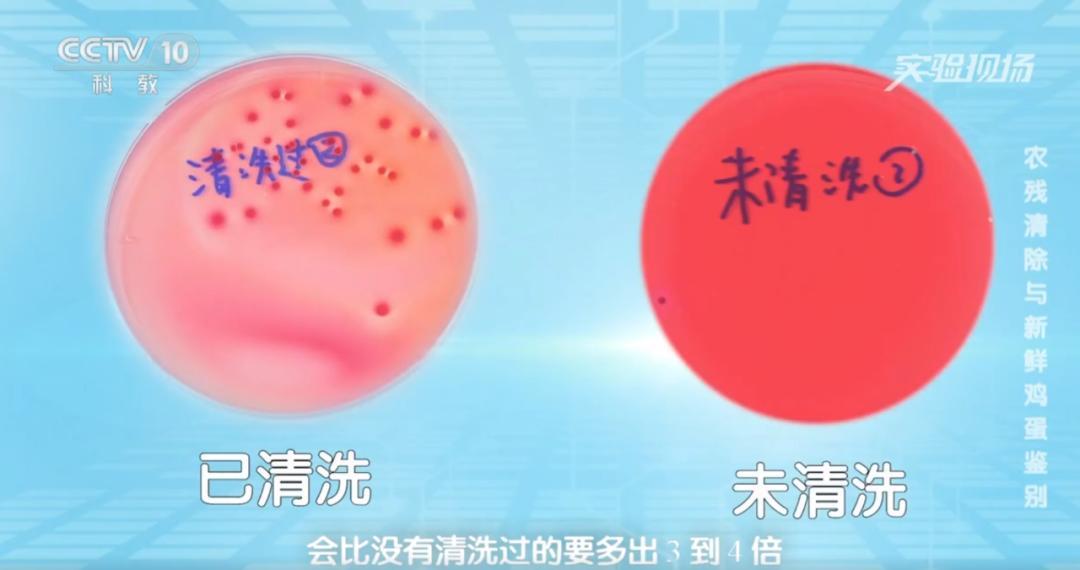

存放雞蛋前多了一個動作,可能喫進致病菌
近日,話題“一家三口吃清洗過的雞蛋後中毒”登上熱搜,引發關注。
很多人認爲,雞蛋經過運輸等流程,表面很髒,洗一洗喫得更放心。但你可能想不到,僅僅因爲存放前的一個多餘動作——清洗雞蛋外殼,就可能加速雞蛋變質,甚至誘發中毒。

爲什麼保存雞蛋前不建議清洗?《生命時報》邀請專家解讀,並教你幾個特徵分辨雞蛋是否變質。
受訪專家
農業農村部食物與營養髮展研究所副研究員 唐振闖
中國農業大學動物科學技術學院教授 徐桂雲
爲什麼存放雞蛋前不能清洗?
爲了食用方便,很多家庭會一次買一大盒雞蛋存起來慢慢喫。但雞蛋屬於生鮮農產品,儲存不當很容易變質,影響口感和安全。
要想讓雞蛋儲存得久且安全,首先要了解它的5個基本特性:
凍裂性
當溫度低於零下7℃時,蛋液容易凍結,造成體積增大,蛋殼破裂。因此,雞蛋不要放入冷凍室保存,也不要太貼近冷藏室內壁。
吸味性
鮮蛋可通過蛋殼上的氣孔和外界不斷進行“呼吸”,極易吸收環境中的異味。如果把雞蛋和香椿、韭菜、大蒜等味道比較重的食材放在一起,很容易串味,影響口感,也更易變質。
因此,買回來的雞蛋要先用食品袋或保鮮盒密封好,再放進冰箱內冷藏。
易腐性
鮮蛋內含豐富的營養物質,易成爲細菌、微生物的天然培養基。當雞蛋所處的環境溫度、溼度過高,或蛋殼破損時,很容易造成大量微生物繁殖,進而導致雞蛋腐敗變質。
易碎性
蛋殼具有一定強度,能承受一定壓力而不受損,保護雞蛋維持固有特性。當雞蛋遭到擠壓、碰撞時,極易造成蛋殼破裂,造成腐敗變質。
易潮性
雞蛋遭到雨淋、水洗、受潮時,會破壞蛋殼表面的膠質薄膜,致使氣孔外露,外界環境中的微生物極易進入蛋內繁殖,加速腐敗。
之所以不要清洗雞蛋後再儲存,是因爲雞蛋表面有一層薄薄的膜,一方面可以阻擋外界細菌進入雞蛋內部,另一方面可以保持雞蛋內部的水分不會流失,從而保持雞蛋的新鮮度,保留其中的營養物質。
用水將雞蛋沖洗後,“白膜”脫落,會造成細菌侵入、水分蒸發,加速雞蛋變質。
據央視科教頻道報道,實驗發現,清洗過外殼的雞蛋菌落比沒有清洗過的多出3~4倍。
雞蛋在出廠前大多已進行清洗、紫外線殺菌、塗油等工序處理,買回家後,可以直接存放,無需清洗。
雞蛋有4種表現,就是變質了嗎?
一些人可能會通過散黃、有裂紋、粘殼等特徵來判斷雞蛋是否變質。徐桂雲教授表示,雞蛋有裂紋、散黃等不一定是變質表現,需要分情況判斷。
散黃
造成雞蛋散黃的原因有很多:
- 在運輸過程中雞蛋受到激烈震盪引起蛋黃膜破裂,這種稱爲機械性散黃,這樣的雞蛋營養價值基本不變,可以放心喫。
- 雞蛋在存放的過程中,蛋白稀化後,水分向蛋黃慢慢滲透,蛋黃體積膨脹到撐破蛋黃膜時,也會發生散黃現象。這樣的雞蛋雖然不太新鮮了,但沒有變質,也可以喫。
- 受過精的雞蛋經過一段時間孵化,蛋黃會發散,可以正常食用。
- 細菌、黴菌通過蛋殼氣孔侵入雞蛋內部,造成雞蛋散黃,甚至蛋黃和蛋清混在一起,這種雞蛋往往帶有異味,不能喫。
如果不清楚是由哪種原因引起散黃蛋,可通過氣味判斷能不能喫。沒有異味的經高溫烹調後可以食用;但若已變臭,說明細菌已在蛋體內繁殖,不能喫。

散長斑
雞蛋長斑通常有兩種情況:
- 存放方式不當或者存放時間過長,導致雞蛋變質,在蛋殼上生出肉眼可見的黑色黴斑,常伴有因變質產生的腐臭味,應避免食用。
- 出現在褐色皮與粉色皮雞蛋上的色素點,常常被稱爲“雀斑”,其主要和產蛋時母雞的身體狀況有關,比如飼料中缺乏維生素A、鈣含量過多等。
此外,初次下蛋時,由於母雞產道狹窄,產道壁被強烈擠壓,造成出血,可能產下少量血斑蛋。因此,如果雞蛋只是表面有少量“雀斑”,其他部位均無異常,說明品質不影響,可以放心喫。
有裂紋
雞蛋營養豐富,一旦外殼出現裂縫、裂紋,很容易被細菌侵入。如果卵殼膜沒破,可儘快加熱後食用。如果卵殼膜破了,就不要喫了。
粘殼
儲存時間過長時,雞蛋的蛋黃膜會由韌變弱,蛋黃緊貼於蛋殼,若局部呈紅色還可以喫;若蛋黃膜緊貼蛋殼不動,貼皮外呈深黑色,有異味的,就不宜再喫。
雞蛋挑選、存放“安全攻略”
購買雞蛋時,建議大家首選正規超市的大品牌產品,生產日期越近越好。如果購買了沒有標註日期的散裝雞蛋,可根據以下幾點判斷是否新鮮:
- 摸一摸:如果雞蛋過於光滑,說明蛋殼膜已經“消失”得差不多了,新鮮度明顯下降。
- 掂一掂:同樣大小的雞蛋,手感越重說明水分蒸發越少,這樣的雞蛋就越新鮮。
- 看一看:透過光看看雞蛋,氣室越小,雞蛋越新鮮。
儲存一段時間後,可通過以下方法觀察雞蛋是否還新鮮:
- 將雞蛋在一個盤子中打開,攤開的面積越小越新鮮;
- 如果能觀察到細細的白色帶子連着蛋黃,說明雞蛋的繫帶尚在,也很新鮮;
- 如果是白煮蛋,蛋黃較居中,蛋白能分離成三層,氣室很小,說明是新鮮的。
雞蛋須儲存在乾燥、清潔、無異味、溫度適宜、通氣良好的地方,且要輕拿輕放,防止蛋殼破裂。存放時還要做到以下幾點,以防提前變質:
保存時間
一般來說,在20℃下,雞蛋保質期爲45天;在0~4℃的環境下雞蛋可保存60天以上。超過保質期,雞蛋的新鮮程度和營養成分都會受到影響。
中國註冊營養師劉萍萍表示,雞蛋如果放在2℃~5℃條件下冷藏,最好在40天內喫完;冬季室溫下儲存,儘量在15天內喫完;夏季室溫下儲存,儘量在10天內喫完。
把雞蛋較大的一端朝上放置
因爲水分和二氧化碳的揮發,雞蛋內部會形成氣室。氣室通常在雞蛋的大頭部位,大頭向上擺放能提高雞蛋內部的穩定性,使得蛋黃不會貼近蛋殼,有利於保證蛋品的質量。
隨取隨用
低溫雞蛋取出後在室溫下會“發汗”,小水滴中的微生物更易透過蛋殼深入到蛋液內層而感染雞蛋。因此,從冰箱中取出的雞蛋不適宜久放,也不適合再放回冰箱冷藏。▲
本期編輯:張宇

















